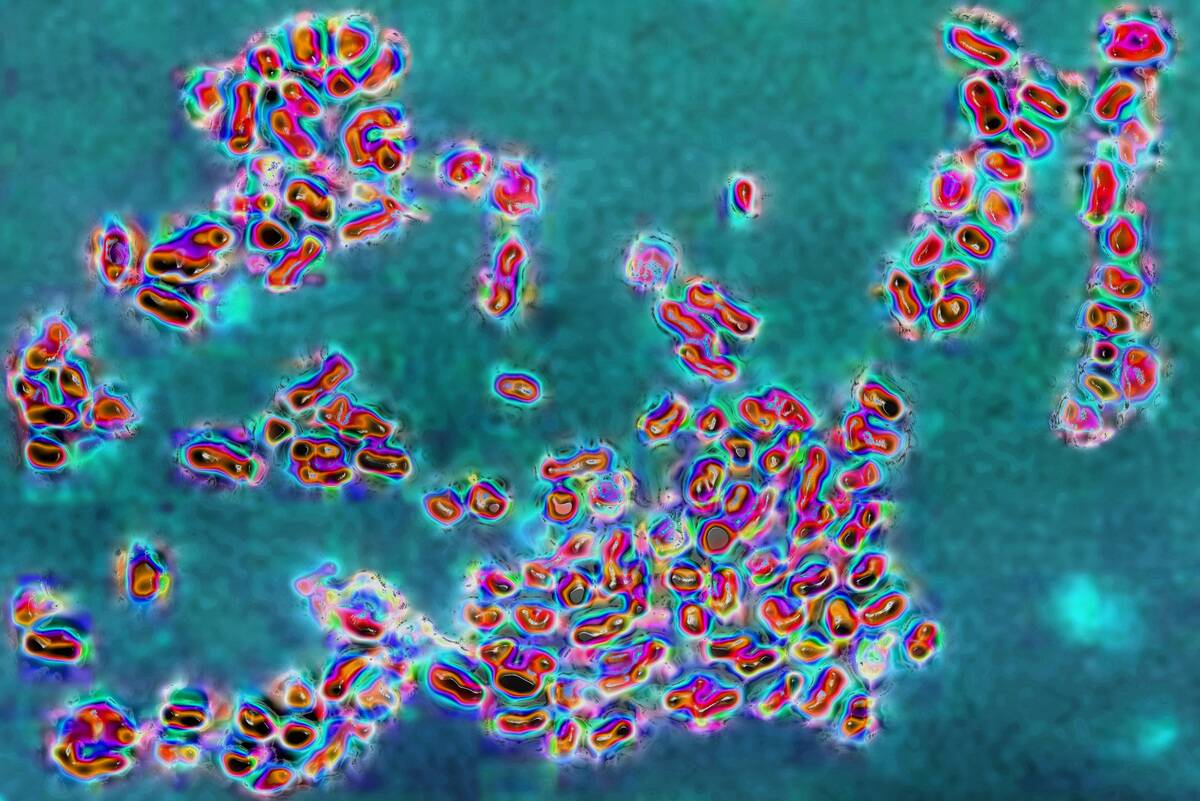
Prevotella bacteria

If You Pass This Medical Terminology Quiz, You’re Probably A Doctor
What part of the body is affected by otitis media?
Retry
Correct
Incorrect
Otitis media refers to a bacterial infection that specifically affects the patient’s middle ear. Since it often involves a buildup of fluid behind the eardrum, it’s imperative to seek medical attention when otitis media occurs because that eardrum can become perforated.
CAVALLINI JAMES/BSIP/Universal Images Group via Getty Images
CAVALLINI JAMES/BSIP/Universal Images Group via Getty Images
What part of the body is affected by otitis media?
- Brain
- Eye
- Stomach
- Ear
Scroll down to continue on!
